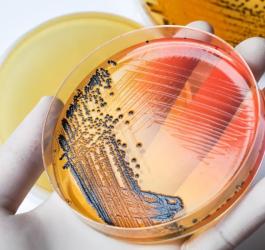
Szalka Petriego, a na niej hodowla bakterii duru brzusznego (łac. Salmonella typhi).

- Polecane
- Endokrynologia
- Okulistyka
- Ortopedia
- Stomatologia
- Alergologia
- Kardiologia
- Ginekologia
- Dermatologia
- Neurologia
- Laryngologia
- Urologia
- Pulmonologia
- Diabetologia
- Zdrowie
- Odżywianie i Diety
- Pediatria
- Badania i diagnostyka
- proktologia
- Psychiatria i psychologia
- Reumatologia
- Hematologia
- Onkologia
- Chirurgia
- Czasopismo OSOZ
- Nefrologia
- Gastrologia
- Medycyna estetyczna